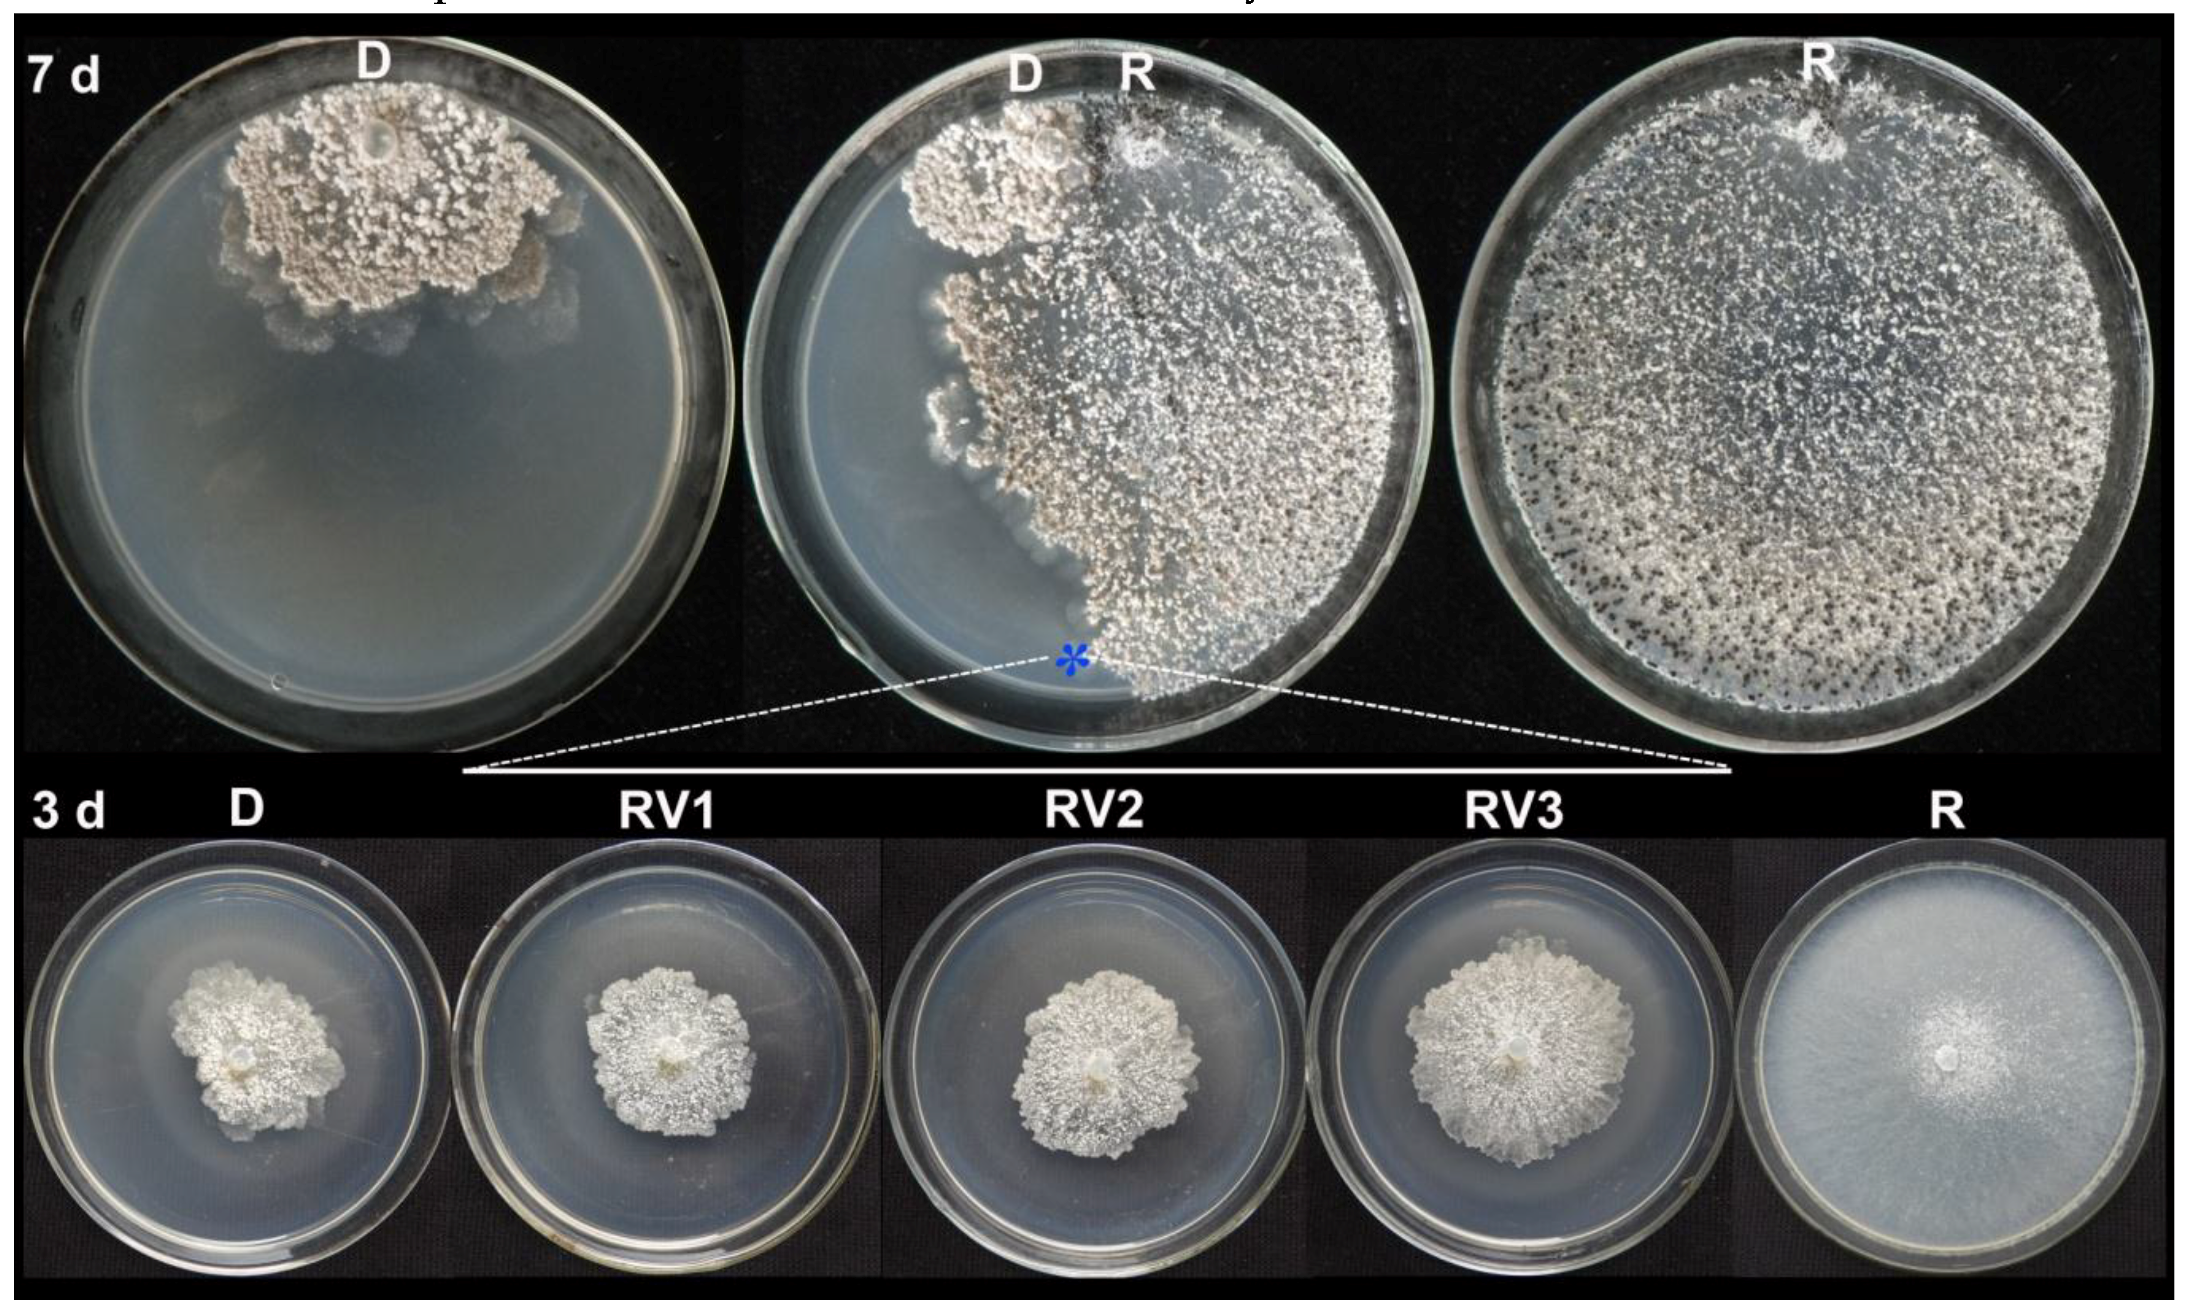
Viruses 10 00589 g003 Viruses 10 00589 g003

Sclerotinia minor Endornavirus 1, a Novel Pathogenicity Debilitation-Associated Mycovirus with a Wide Spectrum of Horizontal Transmissibility
Abstract
1. Introduction
2. Materials and Methods
2.1. Fungal Strains and Cultural Media
2.2. Determination of Mycelial Growth Rate, Sclerotial Production, and Pathogenicity
2.3. Extraction and Identification of dsRNA
2.4. cDNA Cloning and Sequencing of SmEV1
2.5. Sequence Analysis
2.6. Northern Hybridization
2.7. Horizontal Transmission of SmEV1 in S. minor
2.8. Transmission of SmEV1 through Sclerotia
2.9. Extraction of the Total RNA and RT-PCR Detection of SmEV1
2.10. Biocontrol Assay
2.11. Data Analysis
3. Results
3.1. Cultural Characteristics and Pathogenicity of Strain LC22
3.2. DsRNA in Strain LC22 and Its Mycoviral Nature
3.3. Phylogeny of SmEV1/LC22
3.4. Horizontal Transmission of SmEV1
3.5. Transmission of SmEV1 through Sclerotia
3.6. Biocontrol Efficacy of SmEV1
4. Discussion
Supplementary Materials
Author Contributions
Funding
Conflicts of Interest
References
- Ghabrial, S.A.; Suzuki, N. Viruses of plant pathogenic fungi. Annu. Rev. Phytopathol. 2009, 47, 353–384. [Google Scholar] [CrossRef] [PubMed]
- Pearson, M.N.; Beever, R.E.; Boine, B.; Arthur, K. Mycoviruses of filamentous fungi and their relevance to plant pathology. Mol. Plant Pathol. 2009, 10, 115–128. [Google Scholar] [CrossRef] [PubMed]
- Jian, J.; Lakshman, D.K.; Tavantzis, S.M. Association of distinct double-stranded RNAs with enhanced or diminished virulence in Rhizoctonia solani infected potato. Mol. Plant-Microbe Interact. 1997, 10, 1002–1009. [Google Scholar] [CrossRef]
- Ahn, I.P.; Lee, Y.H. A viral double-stranded RNA up regulates the fungal virulence of Nectria radicicola. Mol. Plant-Microbe Interact. 2001, 14, 496–507. [Google Scholar] [CrossRef] [PubMed]
- Schmitt, M.J.; Breinig, F. Yeast viral killer toxins: Lethality and self-protection. Nat. Rev. Microbiol. 2006, 4, 212–221. [Google Scholar] [CrossRef] [PubMed]
- Hollings, M. Viruses associated with a die-back disease of cultivated mushroom. Nature 1962, 196, 962–965. [Google Scholar] [CrossRef]
- Xie, J.T.; Jiang, D.H. New insights into mycoviruses and exploration for the biological control of crop fungal diseases. Annu. Rev. Phytopathol. 2014, 52, 45–68. [Google Scholar] [CrossRef] [PubMed]
- Anagnostakis, S.L. Biological control of chestnut blight. Science 1982, 215, 466–471. [Google Scholar] [CrossRef] [PubMed]
- Milgroom, M.G.; Cortesi, P. Biological control of chestnut blight with hypovirulence: A critical analysis. Annu. Rev. Phytopathol. 2004, 42, 311–338. [Google Scholar] [CrossRef] [PubMed]
- Yu, X.; Li, B.; Fu, Y.P.; Xie, J.T.; Cheng, J.S.; Ghabrial, S.A.; Li, G.Q.; Yi, X.H.; Jiang, D.H. Extracellular transmission of a DNA mycovirus and its use as a natural fungicide. Proc. Natl. Acad. Sci. USA 2013, 110, 1452–1457. [Google Scholar] [CrossRef] [PubMed]
- Nuss, D.L. Hypovirulence: Mycoviruses at the fungal-plant interface. Nat. Rev. Microbiol. 2005, 3, 632–642. [Google Scholar] [CrossRef] [PubMed]
- Yu, X.; Li, B.; Fu, Y.P.; Jiang, D.H.; Ghabrial, S.A.; Li, G.Q.; Peng, Y.L.; Xie, J.T.; Cheng, J.S.; Huang, J.B.; et al. A geminivirus-related DNA mycovirus that confers hypovirulence to a plant pathogenic fungus. Proc. Natl. Acad. Sci. USA 2010, 107, 8387–8392. [Google Scholar] [CrossRef] [PubMed]
- Liu, S.; Xie, J.T.; Cheng, J.S.; Li, B.; Chen, T.; Fu, Y.P.; Li, G.Q.; Wang, M.Q.; Jin, H.N.; Wan, H.; et al. Fungal DNA virus infects a mycophagous insect and utilizes it as a transmission vector. Proc. Natl. Acad. Sci. USA 2016, 113, 12803–12808. [Google Scholar] [CrossRef] [PubMed]
- Biella, S.; Smith, M.L.; Cortesi, P.; Milgroom, M.G. Programmed cell death correlates with virus transmission in a filamentous fungus. Proc. Biol. Sci. 2002, 269, 2269–2276. [Google Scholar] [CrossRef] [PubMed]
- Leslie, J.F. Fungal vegetative compatibility. Annu. Rev. Phytopathol. 1993, 31, 127–150. [Google Scholar] [CrossRef] [PubMed]
- Cortesi, P.; Milgroom, M.G. Genetics of vegetative incompatibility in Cryphonectria parasitica. Appl. Environ. Microbiol. 1998, 64, 2988–2994. [Google Scholar] [PubMed]
- Zhang, D.X.; Nuss, D.L. Engineering super mycovirus donor strains of chestnut blight fungus by systematic disruption of multilocus vic genes. Proc. Natl. Acad. Sci. USA 2016, 113, 2062–2067. [Google Scholar] [CrossRef] [PubMed]
- Wu, S.S.; Cheng, J.S.; Fu, Y.P.; Chen, T.; Jiang, D.H.; Ghabrial, S.A.; Xie, J.T. Virus-mediated suppression of host non-self recognition facilitates horizontal transmission of heterologous viruses. PLoS Pathog. 2017, 13, e1006234. [Google Scholar] [CrossRef] [PubMed]
- Donaire, L.; Pagán, I.; Ayllón, M.A. Characterization of Botrytis cinerea negative-stranded RNA virus 1, a new mycovirus related to plant viruses, and a reconstruction of host pattern evolution in negative-sense ssRNA viruses. Virology 2016, 499, 212–218. [Google Scholar] [CrossRef] [PubMed]
- Liu, L.J.; Xie, J.T.; Cheng, J.S.; Fu, Y.P.; Li, G.Q.; Yi, X.H.; Jiang, D.H. Fungal negative-stranded RNA virus that is related to bornaviruses and nyaviruses. Proc. Natl. Acad. Sci. USA 2014, 111, 12205–12210. [Google Scholar] [CrossRef] [PubMed]
- Valverde, R.A.; Nameth, S.; Abdallha, O.; Al-Musa, O.; Desjardins, P.; Dodds, A. Indigenous double-stranded RNA from pepper (Capsicum annuum). Plant Sci. 1990, 67, 195–201. [Google Scholar] [CrossRef]
- Wakarchuk, D.A.; Hamilton, R.I. Partial nucleotide sequence from enigmatic dsRNA in Phaseolus vulgaris. Plant Mol. Biol. 1990, 14, 637–639. [Google Scholar] [CrossRef] [PubMed]
- Fukuhara, T.; Koga, R.; Aoki, N.; Yuki, C.; Yamamoto, N.; Oyama, N.; Udagawa, T.; Horiuchi, H.; Miyazaki, S.; Higashi, Y.; et al. The wide distribution of endornaviruses, large double-stranded RNA replicons with plasmid-like properties. Arch. Virol. 2006, 151, 995–1002. [Google Scholar] [CrossRef] [PubMed]
- Hacker, C.V.; Brasier, C.M.; Buck, K.W. A double-stranded RNA from a Phytophthora species is related to the plant endornaviruese and contains a putative UDP glycosyltransferase gene. J. Gen. Virol. 2005, 85, 1561–1570. [Google Scholar] [CrossRef] [PubMed]
- Hao, F.M.; Zhou, Z.L.; Wu, M.D.; Li, G.Q. Molecular characterization of a novel endornavirus from the phytopathogenic fungus Botrytis cinerea. Arch. Virol. 2017, 162, 313–316. [Google Scholar] [CrossRef] [PubMed]
- Khalifa, M.E.; Pearson, M.N. Molecular characterisation of an endornavirus infection the phytopathogen Sclerotinia sclerotiorum. Virus Res. 2014, 189, 303–309. [Google Scholar] [CrossRef] [PubMed]
- Li, W.; Zhang, T.; Sun, H.; Deng, Y.; Zhang, A.; Chen, H.; Wang, K. Complete genome sequence of a novel endornavirus in the wheat sharp eyespot pathogen Rhizoctonia cerealis. Arch. Virol. 2014, 159, 1213–1216. [Google Scholar] [CrossRef] [PubMed]
- Osaki, H.; Nakamura, H.; Sasaki, A.; Matsumoto, N.; Yoshida, K. An endornavirus from a hypovirulent strain of the violet root rot fungus, Helicobasidium mompa. Virus Res. 2006, 118, 143–149. [Google Scholar] [CrossRef] [PubMed]
- Roossinck, M.J.; Sabanadzovic, S.; Okada, R.; Valverde, R.A. The remarkable evolutionary history of endornaviruses. J. Gen. Virol. 2011, 92, 2674–2678. [Google Scholar] [CrossRef] [PubMed]
- Okada, R.; Kiyota, E.; Sabanadzovic, S.; Moriyama, H.; Fukuhara, T.; Saha, P.; Roossinck, M.J.; Severin, A.; Valverde, R.A. Bell pepper endornavirus: Molecular and biological properties, and occurrence in the genus Capsicum. J. Gen. Virol. 2011, 92, 2664–2673. [Google Scholar] [CrossRef] [PubMed]
- Okada, R.; Kiyota, E.; Moriyama, H.; Fukuhara, T.; Valverde, R.A. A new endornavirus species infecting Malabar spinach (Basella alba L.). Arch. Virol. 2014, 159, 807–809. [Google Scholar] [CrossRef] [PubMed]
- Chitrampalam, P.; Pryor, B.M. Characterization of mating type (MAT) alleles differentiated by a natural inversion in Sclerotinia minor. Plant Pathol. 2015, 64, 911–920. [Google Scholar] [CrossRef]
- Gaetán, S.A.; Madia, M. Occurrence of sclerotinia stem rot on canola caused by Sclerotinia minor in Argentina. Plant Dis. 2008, 92, 172. [Google Scholar] [CrossRef]
- Li, M.; Zhang, Y.Y.; Wang, K.; Hou, Y.G.; Zhou, H.Y.; Jin, L.; Chen, W.D.; Zhao, J. First report of sunflower white mold caused by Sclerotinia minor Jagger in Inner Mongolia region, China. Plant Dis. 2016, 100, 211. [Google Scholar] [CrossRef]
- Lyu, A.; Zhang, J.; Yang, L.; Li, G.Q. First report of Sclerotinia minor on Brassica rapa subsp. pekinensis in central China. Plant Dis. 2014, 98, 992. [Google Scholar] [CrossRef]
- Melzer, M.S.; Smith, E.A.; Boland, G.J. Index of plant hosts of Sclerotinia minor. Can. J. Plant Pathol. 1997, 19, 272–280. [Google Scholar] [CrossRef]
- Abawi, G.S.; Grogan, R.G. Epidemiology of diseases caused by Sclerotinia species. Phytopathology 1979, 69, 899–904. [Google Scholar] [CrossRef]
- Melzer, M.S.; Boland, G.J. Transmissible hypovirulence in Sclerotinia minor. Can. J. Plant Pathol. 1996, 18, 19–28. [Google Scholar] [CrossRef]
- Yang, D.; Zhang, J.; Wu, M.D.; Chen, W.D.; Li, G.Q.; Yang, L. Characterization of the mycelial compatibility groups and mating type alleles in populations of Sclerotinia minor in central China. Plant Dis. 2016, 100, 2313–2318. [Google Scholar] [CrossRef]
- Hubbard, J.C.; Subbarao, K.V.; Koike, S.T. Development and significance of dicarboximide resistance in Sclerotinia minor isolates from commercial lettuce fields in California. Plant Dis. 1997, 81, 148–153. [Google Scholar] [CrossRef]
- Damicone, J.P.; Jackson, K.E. Effects of application method and rate on control of Sclerotinia blight of peanut with iprodione and fluazinam. Peanut Sci. 2001, 28, 28–33. [Google Scholar] [CrossRef]
- Wu, M.D.; Zhang, L.; Li, G.Q.; Jiang, D.H.; Hou, M.S.; Huang, H.C. Hypovirulence and double-stranded RNA in Botrytis cinerea. Phytopathology 2007, 97, 1590–1599. [Google Scholar] [CrossRef] [PubMed]
- Wu, M.D.; Zhang, L.; Li, G.Q.; Jiang, D.H.; Ghabrial, S.A. Genome characterization of a debilitation-associated mitovirus infecting the phytopathogenic fungus Botrytis cinerea. Virology 2010, 406, 117–126. [Google Scholar] [CrossRef] [PubMed]
- Wu, M.D.; Jin, F.Y.; Zhang, J.; Yang, L.; Jiang, D.H.; Li, G.Q. Characterization of a novel bipartite double-stranded RNA mycovirus conferring hypovirulence in the phytopathogenic fungus Botrytis porri. J. Virol. 2012, 86, 6605–6619. [Google Scholar] [CrossRef] [PubMed]
- Yu, L.; Sang, W.; Wu, M.D.; Zhang, J.; Yang, L.; Zhou, Y.J.; Chen, W.D.; Li, G.Q. Novel hypovirulence-associated RNA mycovirus in the plant-pathogenic fungus Botrytis cinerea: Molecular and biological characterization. Appl. Environ. Microbiol. 2015, 81, 2299–2310. [Google Scholar] [CrossRef] [PubMed]
- Tamura, K.; Peterson, D.; Peterson, N.; Stecher, G.; Nei, M.; Kumar, S. MEGA5: Molecular evolutionary genetic analysis using maximum likelihood, evolutionary distance, and maximum parsimony methods. Mol. Biol. Evol. 2011, 28, 2731–2739. [Google Scholar] [CrossRef] [PubMed]
- Streit, S.; Michalski, C.W.; Erkan, M.; Kleeff, J.; Friess, H. Northern blot analysis for detection and quantification of RNA in pancreatic cancer cells and tissues. Nat. Protoc. 2009, 4, 37–43. [Google Scholar] [CrossRef] [PubMed]
- Fukuhara, T.; Gibbs, M.J. Family Endornaviridae. In Virus Taxonomy: Classification and Nomenclature of Viruses; King, A.M.Q., Adams, M.J., Carstens, E.B., Lefkowitz, E.J., Eds.; Ninth Report of the International Committee on Taxonomy of Viruses; Elsevier Academic Press: London, UK, 2012; pp. 519–521. [Google Scholar]
- Xie, J.T.; Ghabrial, S.A. Molecular characterization of two mitoviruses co-infecting a hypovirulent isolate of the plant pathogenic fungus Sclerotinia sclerotiorum. Virology 2012, 428, 77–85. [Google Scholar] [CrossRef] [PubMed]
- Khalifa, M.E.; Pearson, M.N. Molecular characterisation of three mitoviruses co-infecting a hypovirulent isolate of Sclerotinia sclerotiorum fungus. Virology 2013, 441, 22–30. [Google Scholar] [CrossRef] [PubMed]
- Xiao, X.Q.; Chen, J.S.; Tang, J.H.; Fu, Y.P.; Jiang, D.H.; Baker, T.S.; Ghabrial, S.A.; Xie, J.T. A novel partitivirus that confers hypovirulence on plant pathogenic fungi. J. Virol. 2014, 88, 10120–10133. [Google Scholar] [CrossRef] [PubMed]
- Brasier, C.M. A cytoplasmically transmitted disease of Ceratocysis ulmi. Nature 1983, 305, 220–223. [Google Scholar] [CrossRef]
- Chu, Y.M.; Jeon, J.J.; Yea, S.J.; Kim, Y.H.; Yun, S.H.; Lee, Y.W.; Kim, K.H. Double-stranded RNA mycovirus from Fusarium graminearum. Appl. Environ. Microbiol. 2002, 68, 2529–2534. [Google Scholar] [CrossRef] [PubMed]
- Chiba, S.; Salaipeth, L.; Lin, Y.-H.; Sasaki, A.; Kanematsu, S.; Suzuki, N. A novel bipartite double-stranded RNA mycovirus from the white root rot fungus Rosellinia necatrix: Molecular and biological characterization, taxonomic considerations, and potential for biological control. J. Virol. 2009, 83, 12801–12812. [Google Scholar] [CrossRef] [PubMed]
- Choi, G.H.; Nuss, D.L. Hypovirulence of chestnut blight fungus conferred by an infectious viral cDNA. Science 1992, 257, 800–803. [Google Scholar] [CrossRef] [PubMed]
- Moriyama, H.; Nitta, T.; Fukuhara, T. Double-stranded RNA in rice: A novel RNA replicon in plants. Mol. Gen. Genet. 1995, 248, 364–369. [Google Scholar] [CrossRef] [PubMed]
- Pfeiffer, P. Nucleotide sequence, genetic organization and expression strategy of the double-stranded RNA associated with the ‘447’ cytoplasmic male sterility trait in Vicia faba. J. Gen. Virol. 1998, 79, 2349–2358. [Google Scholar] [CrossRef] [PubMed]
- Moriyama, H.; Horiuchi, H.; Nitta, T.; Fukuhara, T. Unusual inheritance of evolutionarily-related double-stranded RNAs in interspecific hybrid between rice plants Oryza sativa and Oryza rufipogon. Plant Mol. Biol. 1999, 39, 1127–1136. [Google Scholar] [CrossRef] [PubMed]
- Okada, R.; Young, C.K.; Valverde, R.A.; Sabanadzovic, S.; Aoki, N.; Hotate, S.; Kiyota, E.; Moriyama, H.; Fukuhara, T. Molecular characterization of two evolutionarily distinct endornaviruses co-infecting common bean (Phaseolus vulgaris). J. Gen. Virol. 2013, 94, 220–229. [Google Scholar] [CrossRef] [PubMed]
- Tuomivirta, T.T.; Kaitera, J.; Hantula, J. A novel putative virus of Gremmeniella abietina type B (Ascomycota: Helotiaceae) has a composite genome with endornavirus affinities. J. Gen. Virol. 2009, 90, 2299–2305. [Google Scholar] [CrossRef] [PubMed]
- Yaegashi, H.; Kanematsu, S. Natural infection of the soil-borne fungus Rosellinia necatrix with novel mycoviruses under greenhouse conditions. Virus Res. 2016, 219, 83–91. [Google Scholar] [CrossRef] [PubMed]
- Horiuchi, H.; Moriyama, H.; Fukuhara, T. Inheritance of Oryza sativa endornavirus in F1 and F2 hybrids between japonica and indica rice. Genes. Genet. Syst. 2003, 78, 229–234. [Google Scholar] [CrossRef] [PubMed]
- Ikeda, K.; Nakamura, H.; Matsumoto, N. Hypovirulent strain of the violet root rot fungus Helicobasidium mompa. J. Gen. Plant Pathol. 2003, 69, 385–390. [Google Scholar] [CrossRef]
- Roossinck, M.J. Lifestyles of plant viruses. Phil. Trans. R. Soc. B 2010, 365, 1899–1905. [Google Scholar] [CrossRef] [PubMed]

| Recipient Strain (MCG) | SmEV1 1 | Growth Rate (cm/d) 2 | Sclerotia Per Dish 2 | Leaf Lesion Diameter (cm) 3 | ||||
|---|---|---|---|---|---|---|---|---|
| Before | After | Before | After | Before | After | Before | After | |
| LC53 (MCG1) | − | + | 1.8 | 0.6 ** | 1806 | 1259 ** | 4.5 | 1.6 ** |
| XN19 (MCG1) | − | + | 1.8 | 0.7 ** | 2286 | 835 ** | 3.3 | 2.2 ** |
| XN21 (MCG1) | − | + | 1.9 | 0.5 ** | 1881 | 674 ** | 3.6 | 0.4 ** |
| XN35 (MCG1) | − | + | 1.6 | 0.2 ** | 2550 | 1200 * | 2.9 | 0.5 ** |
| DY02 (MCG2) | − | + | 1.5 | 1.0 ** | 1978 | 1411 ** | 3.7 | 1.6 ** |
| LC02 (MCG2) | − | + | 1.7 | 1.1 ** | 2300 | 843 ** | 3.6 | 1.6 ** |
| LC20 (MCG2) | − | + | 1.5 | 0.7 ** | 1719 | 734 ** | 3.1 | 1.0 ** |
| LC28 (MCG2) | − | + | 1.4 | 1.1 ** | 2416 | 1278 * | 3.8 | 0.9 ** |
| LC41 (MCG2) | − | + | 1.8 | 1.2 ** | 2198 | 1196 ** | 3.2 | 0.5 ** |
| LC11 (MCG3) | − | + | 1.6 | 0.3 ** | 2224 | 575 ** | 3.3 | 1.0 ** |
| LC19 (MCG3) | − | + | 1.7 | 0.2 ** | 1742 | 1014 ** | 3.2 | 0.6 ** |
| LC46 (MCG3) | − | + | 1.7 | 0.9 ** | 2432 | 889 ** | 2.6 | 0.8 ** |
| XN01 (MCG3) | − | + | 1.8 | 0.8 ** | 2880 | 1673 ** | 2.5 | 0.6 ** |
| XN12 (MCG4) | − | + | 2.0 | 1.2 ** | 2792 | 1408 ** | 3.9 | 0.2 ** |
| XN13 (MCG4) | − | + | 1.6 | 1.1 ** | 2556 | 1000 ** | 3.5 | 2.4 ** |
| LC15 (MCG5) | − | + | 1.8 | 1.4 ** | 2316 | 1475 ** | 3.4 | 1.3 ** |
| LC38 (MCG5) | − | + | 1.3 | 0.3 ** | 1188 | 674 ** | 0.8 | 0.2 ** |
| XN14 (MCG6) | − | + | 1.7 | 1.4 ** | 2350 | 1225 ** | 2.2 | 1.3 ** |
| XN34 (MCG6) | − | + | 1.8 | 0.4 ** | 1661 | 1124 * | 4.0 | 0.7 ** |
| LC29 (MCG7) | − | + | 2.0 | 0.8 ** | 2492 | 1105 ** | 3.8 | 0.7 ** |
| LC47 (MCG7) | − | + | 2.1 | 1.2 ** | 2459 | 1472 ** | 3.5 | 1.1 ** |
| LC36 (MCG8) | − | + | 1.5 | 0.6 ** | 2691 | 1152 ** | 2.9 | 2.1 ** |
| P13 (MCG9) | − | + | 1.9 | 0.3 ** | 1029 | 528 ** | 3.5 | 0.6 ** |
| W1 (MCG10) | − | + | 1.7 | 0.2 ** | 1788 | 782 ** | 3.7 | 0.7 ** |
| W26 (MCG11) | − | + | 1.6 | 0.3 ** | 1230 | 956 ** | 3.4 | 0.7 ** |
| Virus | Host | Genome Length | Identity (%) | Acc. No. | Presence of Nick | |||
|---|---|---|---|---|---|---|---|---|
| ORF | MTR | Hel | RdRp | |||||
| Botrytis cinerea endornavirus 1 (BcEV1) | F | 11,557 bp | 20.37 | 33.33 | 24.39 | 45.45 | KU923747 | − |
| Alternaria brassicicola endornavirus 1 (AbEV1) | F | 10,290 bp | 15.09 | 30.90 | 24.28 | 32.41 | NC_026136 | ND |
| Tuber aestivum endornavirus (TaEV) | F | 9760 bp | 15.87 | 34.62 | − | 41.18 | NC_014904 | ND |
| Sclerotinia sclerotiorum endornavirus 1/JZJL2 (SsEV1/JZJL2) | F | 10,770 bp | 21.81 | 33.33 | 23.48 | 47.43 | NC_021706 | − |
| Sclerotinia sclerotiorum endornavirus 1/11691 (SsEV1/11691) | F | 10,513 bp | 21.53 | 32.90 | 23.89 | 47.04 | NC_023893 | − |
| Gremmeniella abietina type B RNA virus XL2 (GaBRV/XL2) | F | 10,374 bp | 21.72 | 33.19 | 30.20 | 46.64 | DQ399290 | − |
| Gremmeniella abietina type B RNA virus XL1 (GaBRV/XL1) | F | 10,375 bp | 21.99 | 33.19 | 29.80 | 45.45 | NC_007920 | − |
| Rhizoctonia cerealis endornavirus 1 (RcEV1) | F | 17,486 bp | 9.29 | 15.15 | 17.74 | 25.39 | NC_022619 | − |
| Rhizoctonia solani endornavirus RS002 (RsEV/RS002) | F | 14,694 bp | 9.78 | 18.10 | 18.43 | − | KC792590 | ND |
| Yerba mate endornavirus (YmEV) | P | 13,954 bp | 11.67 | − | 17.32 | 26.56 | NC_024455 | ND |
| Persea americana endornavirus (PaEV) | P | 13,459 bp | 10.75 | − | 15.48 | 24.22 | NC_016648 | ND |
| Oryza rufipogon endornavirus (OrEV) | P | 13,936 bp | 11.71 | − | 15.69 | 25.00 | NC_007649 | + |
| Bell pepper endornavirus (BPEV) | P | 14,728 bp | 12.01 | 17.32 | 17.74 | 27.73 | NC_015781 | ND |
| Oryza sativa endornavirus (OsEV) | P | 13,952 bp | 18.68 | − | 17.65 | 24.61 | D32136 | + |
| Vicia faba endornavirus (VfEV) | P | 17,635 bp | 8.91 | − | 15.63 | 26.95 | AJ000929 | + |
| Phytophthora endornavirus 1 (PEV1) | O | 13,883 bp | 12.59 | − | 16.47 | 26.95 | AJ877914 | + |
| Lagenaria siceraria endornavirus-California (LsEV-CA) | P | 15,088 bp | 10.04 | − | − | 23.92 | NC_023641 | ND |
| Phaseolus vulgaris endornavirus 1 (PvEV1) | P | 13,908 bp | 11.99 | − | 20.00 | 26.17 | AB719397 | + |
| Phaseolus vulgaris endornavirus 2 (PvEV2) | P | 14,820 bp | 11.16 | 19.05 | 20.40 | 26.56 | AB719398 | + |
| Helicobasidium mompa endornavirus 1 (HmEV1) | F | 16,614 bp | 9.88 | − | 17.94 | 26.07 | AB218287 | + |
| Grapevine endophyte endornavirus (GEEV) | P | 12,154 bp | 11.89 | − | 17.53 | 24.71 | NC_019493 | ND |
| Chalara endornavirus (CeEV1) | F | 11,602 bp | 12.48 | − | 19.22 | 26.95 | GQ494150 | ND |
| Basella alba endornavirus-Eclipse (BaEV-E) | P | 14,027 bp | 7.86 | − | 18.50 | 24.61 | AB844264 | + |
| Basella alba endornavirus-Rubra (BaEV-R) | P | 14,027 bp | 7.86 | − | 18.50 | 24.22 | AB844265 | + |
| Erysiphe cichoracearum endornavirus (EcEV) | F | 11,908 bp | 8.71 | − | 18.18 | 24.61 | KT38810 | ND |
| Rosellinia necatrix endornavirus (RnEV1) | F | 9639 bp | 14.45 | 24.03 | 27.98 | 37.65 | LC076696 | − |
| Hordeum vulgare endornavirus (HvEV) | P | 14,243 bp | 7.60 | − | 18.55 | 25.78 | KT721705 | ND |
| Cucumis melo endornavirus (CmEV) | P | 15,078 bp | 9.33 | − | − | 25.10 | KT727022 | ND |
| Hot pepper endornavirus (HPEV) | P | 14,729 bp | 8.6 | 13.87 | − | 26.95 | JN019858 | + |
© 2018 by the authors. Licensee MDPI, Basel, Switzerland. This article is an open access article distributed under the terms and conditions of the Creative Commons Attribution (CC BY) license (http://creativecommons.org/licenses/by/4.0/).
Share and Cite
Yang, D.; Wu, M.; Zhang, J.; Chen, W.; Li, G.; Yang, L. Sclerotinia minor Endornavirus 1, a Novel Pathogenicity Debilitation-Associated Mycovirus with a Wide Spectrum of Horizontal Transmissibility. Viruses 2018, 10, 589. https://doi.org/10.3390/v10110589
Yang D, Wu M, Zhang J, Chen W, Li G, Yang L. Sclerotinia minor Endornavirus 1, a Novel Pathogenicity Debilitation-Associated Mycovirus with a Wide Spectrum of Horizontal Transmissibility. Viruses. 2018; 10(11):589. https://doi.org/10.3390/v10110589
Chicago/Turabian StyleYang, Dan, Mingde Wu, Jing Zhang, Weidong Chen, Guoqing Li, and Long Yang. 2018. "Sclerotinia minor Endornavirus 1, a Novel Pathogenicity Debilitation-Associated Mycovirus with a Wide Spectrum of Horizontal Transmissibility" Viruses 10, no. 11: 589. https://doi.org/10.3390/v10110589
APA StyleYang, D., Wu, M., Zhang, J., Chen, W., Li, G., & Yang, L. (2018). Sclerotinia minor Endornavirus 1, a Novel Pathogenicity Debilitation-Associated Mycovirus with a Wide Spectrum of Horizontal Transmissibility. Viruses, 10(11), 589. https://doi.org/10.3390/v10110589

